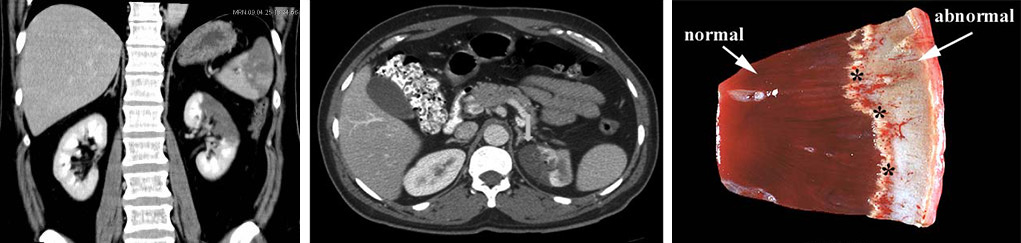
546884846486

Причины инфаркта почки у взрослых
Для возникновения очага некроза в почечной ткани необходимы определенные условия. Почечные артерии — крупные сосуды, поэтому их первичное поражение с развитием инфаркта маловероятно. Значительно большую роль играют заболевания сердца и сосудов, при которых в артерии попадают объекты, закрывающие их.
К основным причинам инфаркта почки можно отнести:
- Пороки сердца;
- Бактериальный эндокардит;
- Гипертонию;
- Атеросклеротические изменения стенок сосудов;
- Инфаркт миокарда;
- Мерцательную аритмию;
- Хирургические вмешательства на аорте и почечных сосудах;
- ДВС-синдром;
- Узелковый периартериит.
Поражения внутреннего слоя сердца (эндокарда), разрушение клапанов и образование тромботических наложений могут привести к попаданию в артериальное русло значительного количества сгустков крови. Эти сгустки способны закупоривать сосуды не только мозга и сердца, но и почек, перемещаясь по аорте к периферии.
Одним из основных осложнений является тромбоэмболический синдром, возникающий из-за внутрисердечного тромбообразования, вызванного нарушением ритма и гемодинамики в сердце. Инфаркт почки — одно из возможных проявлений данного синдрома.
Септический эндокардит сопровождается воспалением внутреннего слоя сердца, что приводит к местному тромбозу. Дальнейшие события развиваются аналогично тем, что наблюдаются при пороках сердца или аритмии.
Инфаркты, особенно трансмуральные и субэндокардиальные, когда воспаляется эндокард, могут привести к образованию тромбов внутри сердца и эмболии других органов.
Атеросклероз — главный «враг» сосудов среди пожилых людей. Его формы не ограничиваются только сердечными или мозговыми поражениями; чаще всего затрагивается аорта, и изменения распространяются на брюшной отдел и уровень отхождения почечных артерий. Закрытие сосуда бляшкой возможно, но чаще происходит ее рост, разрыв и последующий тромбоз, что приводит к инфаркту. Кроме того, атеросклеротические изменения аорты выше места отхождения почечных артерий могут привести к образованию эмболов, которые перемещаются с артериальной кровью и попадают в почечные артерии и их ветви.
Тромбообразование, наблюдаемое в акушерстве, у пациентов с онкогематологическими заболеваниями и при тяжелых шоковых состояниях, может привести к массивному тромбообразованию, где почки становятся мишенью поражения. В таких случаях более характерны кортикальные некрозы, когда зона ишемии охватывает практически весь корковый слой и не ограничивается одним участком, так как множественные тромбы закупоривают не магистральные, а более мелкие сосуды.
Таким образом, в большинстве случаев инфаркт почки обусловлен тромбозом и тромбоэмболией. При этом не имеет большого значения, образовался ли сгусток в самой почечной артерии или пришел из других сосудов. Второй вариант наблюдается даже чаще.
К возможным причинам инфаркта почки также относятся состояния, сопровождающиеся нарушением целостности сосудистых стенок, а также некоторые диагностические процедуры, такие как артериография. В таких случаях происходят местные изменения в стенках сосудов, их воспаление и тромбоз. Если вовлечены почечные артерии, это может привести к инфаркту почки.
Инфаркт почки представляет собой серьезное состояние, возникающее в результате нарушения кровоснабжения почечной ткани. Врачи отмечают, что это может быть вызвано тромбообразованием, эмболией или сужением сосудов. Существует несколько видов инфаркта, включая острый и хронический, каждый из которых имеет свои особенности. Признаки заболевания могут варьироваться от резкой боли в пояснице до повышения артериального давления и наличия крови в моче.
Диагностика включает в себя ультразвуковое исследование, компьютерную томографию и анализы крови. Врачи подчеркивают важность раннего выявления проблемы, так как это напрямую влияет на исход лечения. Лечение может быть консервативным, включая применение антикоагулянтов и препаратов для улучшения кровообращения, или хирургическим, если требуется восстановление проходимости сосудов. Важно, чтобы пациенты обращались за медицинской помощью при первых симптомах, чтобы минимизировать риск осложнений.

Разновидности инфаркта почки
| Аспект инфаркта почки | Описание | Дополнительная информация |
|---|---|---|
| Возникновение | Закупорка артерии, питающей часть почки (чаще всего тромбом или эмболом). Может быть вызвано атеросклерозом, фибрилляцией предсердий, тромбозом глубоких вен, септическим эндокардитом, дегидратацией. | Факторы риска включают гипертонию, диабет, курение, ожирение, заболевания сердца. |
| Виды | Различают инфаркты почек по размеру поражения (ограниченные, обширные), по характеру кровоснабжения (геморрагический, ишемический), по этиологии (тромботический, эмболический). | Классификация важна для прогнозирования и выбора лечения. |
| Признаки и проявления | Боль в пояснице (резкая, постоянная), гематурия (кровь в моче), повышение артериального давления, тошнота, рвота, лихорадка. Может быть бессимптомным, особенно при небольших инфарктах. | Симптомы могут варьировать в зависимости от размера и локализации инфаркта. |
| Диагностика | Анализ крови (лейкоцитоз, повышение СОЭ), анализ мочи (гематурия, протеинурия), УЗИ почек (выявление зоны пониженной эхогенности), КТ или МРТ почек (более точная визуализация инфаркта), ангиография почечных артерий (для подтверждения диагноза и оценки степени поражения). | Диагностика может быть сложной, особенно на ранних стадиях. |
| Лечение | Консервативное лечение (борьба с болью, контроль артериального давления, антикоагулянты для предотвращения дальнейшего тромбообразования, поддержка функции почек). В некоторых случаях может потребоваться хирургическое вмешательство (тромболизис, ангиопластика). | Лечение направлено на предотвращение осложнений и сохранение функции почки. Прогноз зависит от размера инфаркта и наличия сопутствующих заболеваний. |
Инфаркт почки у взрослых
В зависимости от механизма формирования очага некроза почечной паренхимы различают два типа: белый (ишемический) и красный (геморрагический) инфаркт.
- Геморрагический инфаркт возникает при нарушениях венозной системы. Закупорка вен затрудняет отток венозной крови, что приводит к накоплению крови выше места повреждения. Это вызывает гибель клеток и придаёт инфаркту красный оттенок. Красные инфаркты не характерны для почек, но иногда встречаются.
- Ишемический инфаркт почки — более распространённый тип, возникающий при блокировке артериального сосуда. В этом случае прекращается поступление крови в ткань, развивается ишемия, и клетки погибают. Участок некроза становится белым из-за отсутствия кровоснабжения.
Характеристика кровотока в органе (магистральный тип) влияет на внешний вид инфаркта почки. Обычно он имеет клиновидную форму светлого цвета, иногда с венчиком кровоизлияний по краям, с четкими границами. Основание направлено к периферии, а острие — к воротам почки, где крупные артерии делятся на более мелкие. Образование геморрагического венчика связано с тем, что спазм артерий на краях некротического участка сменяется их резким расширением, что приводит к выходу кровяных клеток из сосудов.
В зависимости от степени распространенности некроза инфаркт может быть ограничен корковым слоем или затрагивать мозговое вещество, принимая форму конуса, направленного к периферии органа. При закрытии главной артерии, питающей почку, может возникнуть субтотальный или тотальный инфаркт, охватывающий всю почку.
Микроскопические изменения включают гибель клеток, отек, кровоизлияния и разрушение межклеточного вещества и соединительных волокон. В первую очередь страдают почечные канальцы, отвечающие за выведение мочи, так как они наиболее нагружены функционально. Ткань в области некроза принимает вид однородных масс с обломками клеток, а в ответ на разрушение развивается воспалительная реакция с участием лейкоцитов.
Инфаркт почки — это серьезное заболевание, возникающее в результате нарушения кровоснабжения почечной ткани. Люди часто отмечают, что основными причинами этого состояния являются тромбы, атеросклероз и сосудистые заболевания. Существует несколько видов инфаркта, включая острый и хронический, каждый из которых имеет свои особенности. Признаки могут варьироваться от резкой боли в пояснице до повышения артериального давления и появления крови в моче. Диагностика включает ультразвуковое исследование, компьютерную томографию и анализы крови. Лечение зависит от степени повреждения почки и может включать медикаментозную терапию, а в тяжелых случаях — хирургическое вмешательство. Важно своевременно обращаться к врачу при первых симптомах, чтобы избежать серьезных последствий.

Инфаркты почек в педиатрии
У детей могут возникать инфаркты почек. Эти случаи чаще наблюдаются у пациентов с врожденными аномалиями сердца или поражением клапанов на фоне ревматизма, то есть у детей с предрасполагающими заболеваниями. Особое внимание стоит уделить мочекислому инфаркту почки.
Это состояние чаще всего встречается у новорожденных и является проблемой, с которой сталкиваются врачи-неонатологи. Мочекислый инфаркт — это реакция организма ребенка на новые условия и начало самостоятельного формирования и выведения мочи. Нестабильность буферных систем крови и небольшой объем жидкости, выводимой почками, могут приводить к осаждению солей мочевой кислоты в почечной ткани.
Мочекислые инфаркты возникают в первые дни жизни новорожденного, и по мере адаптации почек к самостоятельной функции их проявления постепенно исчезают, что не представляет опасности для здоровья ребенка. Проблемой считается ситуация, когда мочекислый инфаркт сохраняется после десятого дня жизни. Молодым матерям не следует паниковать, но стоит сообщить врачу о любых изменениях в моче младенца.
Проявления инфаркта почки
Симптоматика инфаркта почки зависит от объема пораженной паренхимы. Если некротический участок небольшой, клинические проявления могут отсутствовать, и пациент зачастую не подозревает о проблеме.
При значительных инфарктах нарушения функции почек становятся очевидными, и возникают следующие клинические признаки:
- Боль в области поясницы;
- Лихорадка;
- Гематурия;
- Повышение артериального давления;
- Уменьшение объема мочи.
Температура тела может повышаться до субфебрильных значений (обычно не превышая 38°С), что свидетельствует о воспалительной реакции организма. Это проявляется примерно на второй-третий день после начала некроза в почке. Пациенты могут испытывать озноб, нарастающие симптомы интоксикации и болезненные ощущения. В моче могут появляться видимые сгустки крови (макрогематурия), которые могут сохраняться в течение 3-5 дней. После этого эритроциты становятся видимыми только под микроскопом.
Эти симптомы чаще всего наблюдаются при белом (анемическом) инфаркте. Венозные некрозы протекают тяжелее, с постепенным нарастанием симптомов. Заболевание начинается с повышения температуры, к которому добавляются озноб, выраженная слабость, беспокойство и болезненные ощущения в пояснице, а также учащение пульса. Гематурия при венозных инфарктах выражена значительно сильнее, и наличие кровяных сгустков может привести к тампонаде мочевого пузыря. В результате некроза паренхимы резко снижается объем образуемой мочи, который зачастую не превышает 150 мл в сутки.
При мочекислых инфарктах у новорожденных общее состояние остается стабильным, а единственным признаком является темная или кирпичного цвета моча на пеленке или подгузнике.

Диагностика и лечение инфаркта почки
Диагностика инфаркта почки проводится урологом или хирургом. Она основывается на клиническом осмотре, анализе симптомов, лабораторных данных и других исследованиях. Обязательным является общий анализ мочи, в котором могут быть выявлены эритроциты, лейкоциты и гиалиновые цилиндры. При анализе крови обращают внимание на увеличение количества лейкоцитов и ускорение скорости оседания эритроцитов (СОЭ). Биохимический анализ крови может показать повышение уровня фермента ЛДГ, что указывает на некротические изменения в почках.
Среди инструментальных методов диагностики особое значение имеет ультразвуковое исследование с допплерографией. Оно информативно и может проводиться круглосуточно в большинстве медицинских учреждений. Ангиография считается «золотым стандартом» для диагностики артериальных некрозов, но её применение ограничено.
Лечение инфаркта почки осуществляется только в стационаре, и пациенту необходим строгий постельный режим. При подозрении на заболевание терапия назначается урологом и может быть медикаментозной или хирургической.
Медикаментозная терапия направлена на восстановление кровотока в закупоренном сосуде, снятие сосудистого спазма и устранение уродинамических нарушений. В случае инфекционных осложнений требуется антибактериальная терапия.
Для облегчения болевого синдрома назначаются анальгетики, включая наркотические (морфин, омнопон). Тромболитики (стрептокиназа) используются для растворения тромбов, а антикоагулянты (гепарин, клексан) назначаются для профилактики тромбообразования. Антикоагулянтная терапия должна начинаться как можно раньше, чтобы предотвратить необратимые изменения в почечной ткани. При выраженной гематурии показаны гемостатики, такие как этамзилат натрия.
Для предотвращения обезвоживания необходимо обеспечить достаточное потребление жидкости. Внутривенные инфузии помогают справиться с сгущением крови, гипотонией и ацидозом, вызванным накоплением кислых продуктов обмена.
При тяжелых инфарктах может потребоваться нефрэктомия (удаление почки), если некроз охватывает весь орган. В других случаях применяются менее инвазивные методы, такие как баллонная ангиопластика и тромбэктомия.
Для облегчения выведения излишков мочевой кислоты ребенку необходимо обеспечить достаточное количество жидкости, возможно, допаивание кипяченой водой.
Прогноз при инфаркте почки, как правило, благоприятный. Своевременное лечение позволяет восстановить функцию органа, а на месте омертвевшей ткани образуется рубец. Окружающие ткани могут компенсировать утрату функции, что позволяет сохранять образование мочи на приемлемом уровне. Однако риск повторных тромбозов и эмболий, особенно при наличии предрасполагающих факторов, требует назначения антиагрегантов на длительный срок или даже пожизненно.
Для профилактики инфаркта почки важно следить за состоянием сердечно-сосудистой системы, предотвращая атеросклеротические изменения с помощью статинов, фибратов и диеты. При наличии сердечных пороков, искусственных клапанов и аритмий назначение антиагрегантов (аспирин, клопидогрель, варфарин) является обязательным.
Вопрос-ответ
Каковы симптомы инфаркта почек?
Симптомы инфаркта почек могут включать резкую боль в пояснице или боку, которая может иррадиировать в живот или пах, а также возможное появление крови в моче, снижение объема мочи, тошноту и рвоту. В некоторых случаях может наблюдаться повышение артериального давления и общее ухудшение состояния.
Каковы симптомы инфаркта почки?
Боль в паху, постоянная и часто сопровождающаяся тошнотой или рвотой, по-видимому, является наиболее распространённым начальным симптомом. Другие жалобы включают боль в животе, спине или груди. Небольшие инфаркты почек могут протекать безболезненно, а у некоторых пациентов наблюдается лишь утомляемость.
Какая диагностика при инфаркте?
Диагностика инфаркта миокарда в «СМ-Клиника». Лабораторные обследования: анализ крови общий, биохимический и на кардиотропные белки (MB-КФК, АсАТ, ЛДГ-1, тропонин). Инструментальные исследования: ЭКГ, компьютерная томография, МРТ, ангиография, коронография, ультразвуковое исследование сонных артерий.
Каковы причины мочекислого инфаркта?
Мочекислый инфаркт (мочекислый диатез). Это состояние развивается у трети детей 1-й недели жизни в результате отложения кристаллов мочевой кислоты. Причина — распад большого количества клеток, из ядер которых высвобождаются азотистые вещества, что и придает моче кирпичный оттенок. Лечение не требуется.
Советы
СОВЕТ №1
Регулярно проходите медицинские обследования, особенно если у вас есть факторы риска, такие как высокое кровяное давление или диабет. Раннее выявление проблем с почками может значительно повысить шансы на успешное лечение.
СОВЕТ №2
Обратите внимание на свое питание. Употребление продуктов с низким содержанием натрия и высоким содержанием клетчатки поможет поддерживать здоровье почек. Избегайте избыточного потребления алкоголя и обработанных продуктов.
СОВЕТ №3
Следите за уровнем жидкости в организме. Достаточное потребление воды помогает поддерживать нормальную функцию почек и предотвращает образование камней. Однако, если у вас уже есть проблемы с почками, проконсультируйтесь с врачом о необходимом количестве жидкости.
СОВЕТ №4
Не игнорируйте симптомы, такие как боль в пояснице, отеки или изменения в мочеиспускании. Если вы заметили что-либо необычное, немедленно обратитесь к врачу для диагностики и лечения.